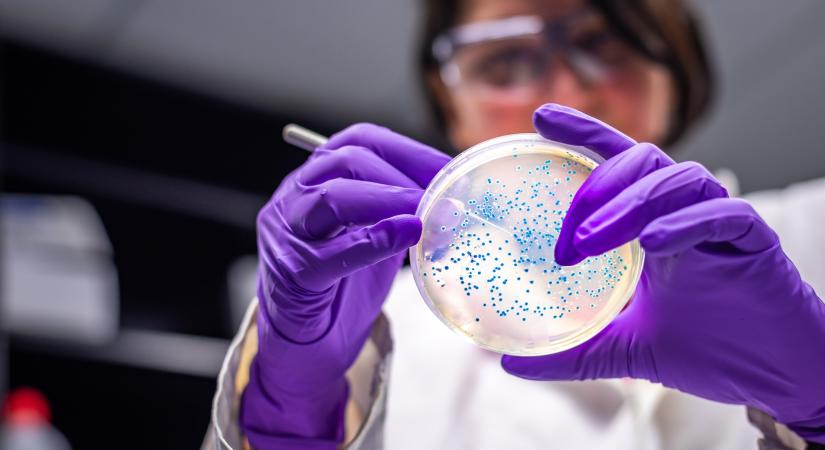
Egészen hihetetlen, hogy mi válhat 2050-re vezető halálokká

Egészen hihetetlen, hogy mi válhat 2050-re vezető halálokká
A Szegedi Tudományegyetem (SZTE), a temesvári Victor Babeş Orvosi és Gyógyszerészeti Egyetem és az OncoHelp Egyesület részvételével indult egy 2028 elejéig tartó projekt, amely az antibiotikum-rezisztencia elleni hatékony fellépést segíti.
- Hirdetés -